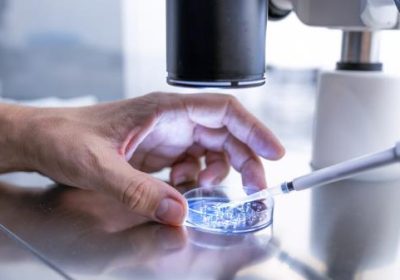

ATEEZ、&TEAM、Hearts2Hearts确认闪耀“ASEA 2026”!亚洲顶级音乐盛典阵容再升级!
代表亚洲的顶级艺人们即将齐聚一堂!第三届“亚洲明星艺人奖2026”(简称ASEA 2026)音乐盛典,定于5月16日至17日在日本埼玉县贝尔纳巨蛋隆重举行。组委会于3月12日正式宣布,ATEEZ、&TEAM以及Hearts2Hearts已确认加盟演出,引爆全网期待!
ATEEZ(成员:洪中、星和、然俊、余尚、山、民基、宇英、宗浩)去年凭借第12张迷你专辑《Golden Hour: Part.3》及其改版专辑《Golden Hour: Part.3 "In Your Fantasy Edition"》血洗全球榜单。更猛的是,今年2月发行的第13张迷你专辑《Golden Hour: Part.4》直接达成累计第六张“百万销量”专辑,坐实K-POP领军地位!从去年7月启动的“In Your Fantasy”世界巡演,横扫北美12城、日本3城后,现已扩张至亚洲和澳洲,这现场实力,妥妥的“舞台王者”没跑了!
&TEAM(成员:宇周、风马、K、NICHOLAS、悠真、JO、春亚、TAKI、MAKI)作为HYBE于2022年推出的首支日本团体,去年10月以韩语出道专辑《Back to Life》成功打开韩国市场。专辑发行首日即破百万销量,Circle Chart累计出货量高达1,331,733张,强势跻身顶级梯队!不仅拿下韩国音乐节目一位,更闯进美国Billboard榜单,并在日本Oricon榜夺冠,全球战绩亮眼。正在筹备亚洲巡演的他们,将于4月发行第三张日文迷你专辑《We on Fire》,热度持续引爆!
Hearts2Hearts(成员:志雨、CARMEN、有花、STELLA、周恩、AINA、IAN、艺恩)是SM娱乐自少女时代后,时隔多年推出的多人组新锐女团,此次将是连续第二年登上ASEA舞台。去年斩获新人奖后,出道曲《The Chase》在Spotify上狂揽1亿流媒体播放量,“最强新人”实至名归!近期迎来出道一周年的她们,凭借新曲《RUDE!》席卷国内音源榜前列,刷新自身纪录,不仅收获音乐节目一位,更在全球榜单上表现抢眼。今年2月举办的首场粉丝见面会,连视野受限席都全部售罄,这票房号召力,绝了!
自2024年创立以来,“ASEA”已成为一个精选并表彰在亚洲乃至全球具有影响力的艺人、呈现高水平演出的国际性颁奖礼。今年,预计将有更多在过去一年取得瞩目成绩的顶级艺人加入这场盛宴。
“ASEA 2026”由迎来创刊21周年的韩国代表娱乐体育专业媒体“NEWSEN”,与迎来创刊14周年的明星风格专业杂志“@style”共同主办,ASEA组委会负责组织。
“ASEA 2026”的艺人阵容、奖项类别及评审标准等更多详细信息,将通过官方渠道陆续公布,敬请持续关注!
KQ娱乐,YX Labels,SM娱乐